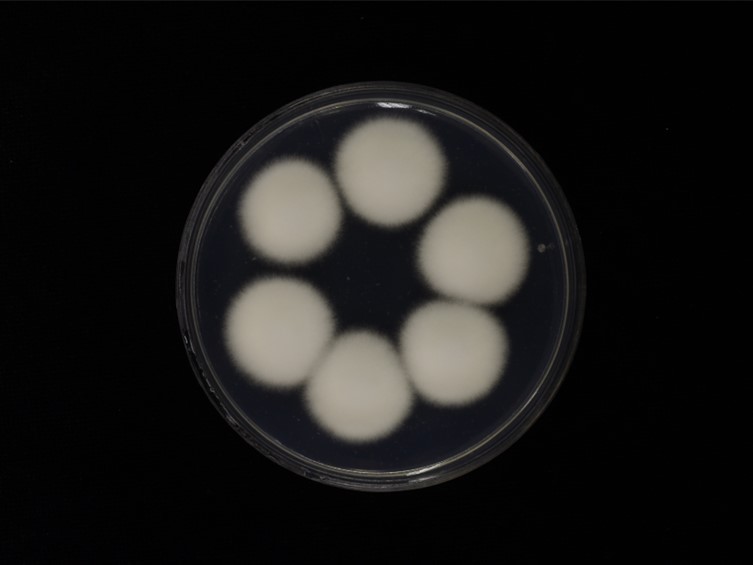

Holotype:
THAILAND, Chiang Mai Province, Doi Inthanon National Park, 18 Nov. 2015, K. Tasanathai, S. Mongkolsamrit, D. Thanakitpipattana, W. Noisripoom, R. Promharn, P. Srikitikulchai, S. Wongkanoun, holotype BBH 41223, ex-type living culture TBRC 7915.
Habitat:
Leaf litter.
Host:
Lepidopteran larva, pupa.
Description:
 Stromata gregarious, up to 20-50 mm long and 1-1.5 mm broad, cylindrical to clavate. Rhizoids flexuous, arising from the insect host (body size 23-25 × 7-8 mm), ca 2-4 cm long under the ground. Upper part of the stromata fertile, orange red, 8-15 mm long, 1.5-2 mm broad.
Stromata gregarious, up to 20-50 mm long and 1-1.5 mm broad, cylindrical to clavate. Rhizoids flexuous, arising from the insect host (body size 23-25 × 7-8 mm), ca 2-4 cm long under the ground. Upper part of the stromata fertile, orange red, 8-15 mm long, 1.5-2 mm broad.  Perithecia superficial, ovoid, 380-500 × 150-265 μm.
Perithecia superficial, ovoid, 380-500 × 150-265 μm.  Asci cylindrical, 8-spored, up to 300 × 2-2.5 μm.
Asci cylindrical, 8-spored, up to 300 × 2-2.5 μm.  Ascospore hyaline, whole, bola-shaped, 3- or 4-septate, 200-275 × 0.5-1 μm, central part filiform, terminal part very narrowly fusiform, 30-55 × 1-1.5 μm.
Ascospore hyaline, whole, bola-shaped, 3- or 4-septate, 200-275 × 0.5-1 μm, central part filiform, terminal part very narrowly fusiform, 30-55 × 1-1.5 μm.
Culture characteristics:
Colonies on PDA moderately fast-growing, ca 3 cm diam in 14 d at 25 °C, light orange, cottony with high mycelial density, becoming white around the center of colonies when sporulating abundantly in 30 d, reverse at first unpigmented and turning deep yellow to orange in 30 d. Prostrate hyphae smooth, septate, hyaline, 2–3 μm diam. Conidial structures consisting of erect conidiophores borne on aerial or vegetative hyphae, verticillate with phialides in whorls of two to five. Some phialides borne directly and singly on aerial hyphae. Phialides 4–12 × 1–3 μm, cylindrical basal portion, tapering into a long neck, 1–4 × 0.5–1 μm. Conidia in chains, hyaline, short fusiform, 1-celled, 2–3.5 × 1.5–2 μm. Chlamydospores and synnemata not observed.
Colonies on PDA moderately fast-growing, ca 3 cm diam in 14 d at 25 °C, light orange, cottony with high mycelial density, becoming white around the center of colonies when sporulating abundantly in 30 d, reverse at first unpigmented and turning deep yellow to orange in 30 d. Prostrate hyphae smooth, septate, hyaline, 2–3 μm diam. Conidial structures consisting of erect conidiophores borne on aerial or vegetative hyphae, verticillate with phialides in whorls of two to five. Some phialides borne directly and singly on aerial hyphae. Phialides 4–12 × 1–3 μm, cylindrical basal portion, tapering into a long neck, 1–4 × 0.5–1 μm. Conidia in chains, hyaline, short fusiform, 1-celled, 2–3.5 × 1.5–2 μm. Chlamydospores and synnemata not observed.
Reference:
Mongkolsamrit S, Noisripooma W, Thanakitpipattana D, et al. (2018). Disentangling cryptic species with isaria-like morphs in Cordycipitaceae. Mycologia 110: 230–257.
DOI: https://doi.org/10.1080/00275514.2018.1446651Species |
Strain |
Compound |
Pubchem CID |
Biological activity |
Reference |
|---|
|
Strain |
ITS | LSU | RPB1 | RPB2 | TEF1 |
|---|---|---|---|---|---|
| TBRC 7915 | MF140761 | MF140725 | MF140790 | MF140815 | MF140849 |
| TBRC 7916 | MF140760 | MF140724 | MF140789 | MF140814 | MF140848 |
| TBRC 7970 | MF140759 | MF140723 | MF140788 | MF140813 | MF140847 |